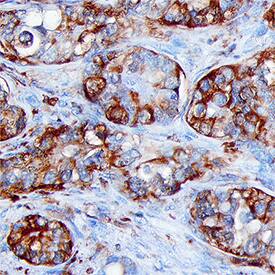
FBPase 1 antibody in Human Liver Cancer Tissue by Immunohistochemistry (IHC-P).

Human/Mouse/Rat FBPase 1 Antibody
R&D Systems, part of Bio-Techne | Catalog # AF7285


Key Product Details
Species Reactivity
Applications
Label
Antibody Source
Product Specifications
Immunogen
Ala2-Gln338 (Arg218Lys)
Accession # P09467
Specificity
Clonality
Host
Isotype
Scientific Data Images for Human/Mouse/Rat FBPase 1 Antibody
Detection of Human, Mouse, and Rat FBPase 1 by Western Blot.
Western blot shows lysates of MCF-7 human breast cancer cell line, mouse liver tissue, and rat liver tissue. PVDF membrane was probed with 0.2 µg/mL of Sheep Anti-Human/Mouse/Rat FBPase 1 Antigen Affinity-purified Polyclonal Antibody (Catalog # AF7285) followed by HRP-conjugated Anti-Sheep IgG Secondary Antibody (Catalog # HAF016). A specific band was detected for FBPase 1 at approximately 37 kDa (as indicated). This experiment was conducted under reducing conditions and using Immunoblot Buffer Group 1.FBPase 1 in Human Liver Cancer Tissue.
FBPase 1 was detected in immersion fixed paraffin-embedded sections of human liver cancer tissue using Sheep Anti-Human/Mouse/Rat FBPase 1 Antigen Affinity-purified Polyclonal Antibody (Catalog # AF7285) at 15 µg/mL for 1 hour at room temperature followed by incubation with the Anti-Sheep IgG VisUCyte™ HRP Polymer Antibody (Catalog # VC006). Tissue was stained using DAB (brown) and counterstained with hematoxylin (blue). Specific staining was localized to cytoplasm in cancer cells. View our protocol for IHC Staining with VisUCyte HRP Polymer Detection Reagents.Applications for Human/Mouse/Rat FBPase 1 Antibody
Immunohistochemistry
Sample: Immersion fixed paraffin-embedded sections of human liver cancer tissue
Western Blot
Sample: MCF‑7 human breast cancer cell line, mouse liver tissue, and rat liver tissue
Formulation, Preparation, and Storage
Purification
Reconstitution
Formulation
Shipping
Stability & Storage
- 12 months from date of receipt, -20 to -70 °C as supplied.
- 1 month, 2 to 8 °C under sterile conditions after reconstitution.
- 6 months, -20 to -70 °C under sterile conditions after reconstitution.
Background: FBPase 1
FBPase 1 (Fructose 1,6 bisphosphatase 1 [Fru-1,6-P2ase]; also FBP-1 phosphohydrolase 1) is a 35-37 kDa member of the FBPase Class I family of enzymes. It is widely expressed, being found in cells diverse as monocytes, hepatocytes, pancreatic beta-cells and striated (skeletal plus cardiac) muscle cells. FBPase 1 converts Fru-1,6-P2 into Fru-6-P, a molecule that is subsequently used to generate glucose. Human FBPase 1 is 338 amino acids (aa) in length. It contains one catalytic region (aa 18-332) and an NLS between aa 203-208. FBPase 1 exhibits divalent cation dependency, and exists as a homotetramer within the cell. Full-length human FBPase 1 shares 85% aa sequence identity with mouse FBPase 1.
Long Name
Alternate Names
Gene Symbol
UniProt
Additional FBPase 1 Products
Product Documents for Human/Mouse/Rat FBPase 1 Antibody
Product Specific Notices for Human/Mouse/Rat FBPase 1 Antibody
For research use only